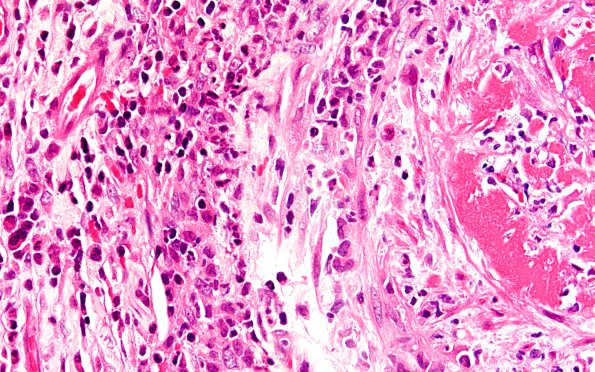
1A3 PAN (Case 1) H&E 20X 1

Table of Contents
Washington University Experience | PERIPHERAL NEUROPATHY | 11 VASCULITIS - VASCULOPATHY | 4 Polyarteritis nodosa | 1A3 PAN (Case 1) H&E 20X 1
The structure of this arteriole is completely lost, replaced by a mixture of inflammatory cells including lymphocytes, PMNs and occasional plasma cells. Fibrin deposition is prominent. Hemorrhage is frequently seen accompanied by thrombosis. (H&E)